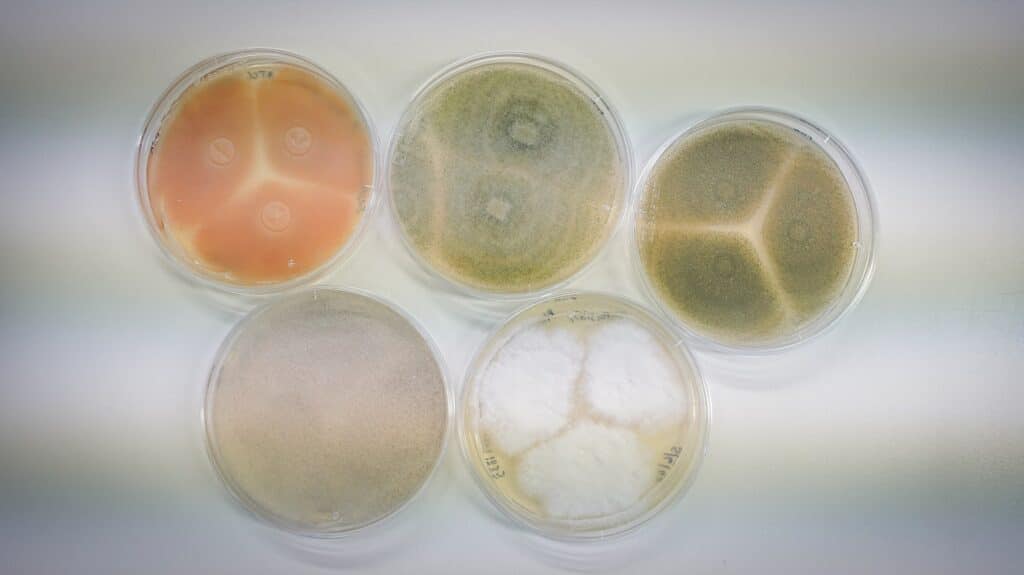

¿Es posible desarrollar grasas más saludables y sostenibles sin renunciar a la funcionalidad ni al sabor? En el proyecto BOILÀ hemos demostrado que sí. A través de tecnologías innovadoras como la extracción de oleosomas, la oleogelación proteica y la producción de lípidos mediante fermentación microbiana, hemos generado nuevas estructuras grasas con menor impacto ambiental y mejor perfil nutricional. En este artículo te contamos cómo lo hemos hecho, qué retos hemos superado y qué aplicaciones reales hemos conseguido en colaboración con la industria alimentaria. Descúbrelo a continuación.
El objetivo del proyecto BOILÀ nos ha permitido generar nuevas estructuras grasas más sostenibles y saludables a través de la aplicación de nuevas vías tecnológicas de desarrollo. Para ello, hemos profundizado en las siguientes estrategias innovadoras:
- Extracción avanzada de oleosomas a partir de semilla oleaginosas
- Oleogelación proteica de aceites vegetales
- Producción biotecnológica de lípidos
Dichos desarrollos responden a la tendencia actual del mercado hacia el consumo de productos más saludables y sostenibles, como el caso de los alimentos plant-based. Estas tipologías de productos no sólo son consumidas por la población vegana y vegetariana, sino que su principal nicho reside en los flexitarianos, aquellas personas omnívoras que buscan reducir la ingesta de alimentos de origen animal por los motivos anteriormente mencionados. Por otro lado, los consumidores no están dispuestos a renunciar a la calidad de los productos, incluso cuando buscan opciones más saludables y sostenibles; el componente hedónico continúa siendo un factor decisivo en la elección de los alimentos.
En este paradigma aparecen las grasas vegetales sólidas, como coco y palma, por su aptitud tecnológica y organoléptica como alternativa a las de origen animal, tales como la mantequilla y la manteca. Sin embargo, éstas llevan asociadas no sólo una elevada presencia de ácidos grasos saturados, relacionados, entre otros, con el aumento de riesgo cardiovascular, sino también con problemas medioambientales, como la deforestación. O las grasas hidrogenadas, cada vez más en desuso, por su contenido en ácidos grasos trans, cuyo consumo también ha sido asociado al aumento de diversas enfermedades.
Si bien existen otras fuentes lipídicas en el reino vegetal con mejor perfil nutricional, aquellas ricas en ácidos grasos insaturados, como es el caso de los aceites vegetales, dicha insaturación implica, a su vez, su consistencia líquida a temperatura ambiente. En la Industria Alimentaria un ingrediente aporta numerosos matices en una formulación. En concreto, los lípidos juegan un papel tecnológico y sensorial muy importante, ya que las grasas saturadas (sólidas a temperatura ambiente) aportan textura, untabilidad, y palatabilidad a los alimentos.
En este sentido, encontrar alternativas grasas más saludables y sostenibles, pero sin renunciar al aporte organoléptico y tecnológico, se presenta como un desafío que hemos abordado desde AINIA con el proyecto BOILÀ.
Obtención de oleosomas a partir de semillas oleaginosas empleando procesos de prensado en frío
Una de las actividades desarrolladas en el proyecto BOILÀ ha consistido en la extracción de oleosomas, estructuras naturales presentes en las semillas oleaginosas. Los oleosomas son gotas microscópicas de aceite rodeadas por una membrana de fosfolípidos y proteínas, lo que les proporciona una gran estabilidad y funcionalidad. En este proyecto, se han extraído con éxito mediante prensado en frío, seguido de otras técnicas de separación y acondicionado como centrifugación. filtración con membranas o ultrasonidos.
El proceso se ha aplicado a semillas de uva y calabaza, subproductos de la industria agroalimentaria, lo que contribuye así a la economía circular mediante la valorización de estos residuos.
En este sentido, se ha logrado obtener productos finales con un alto contenido en oleosomas, lo que resulta especialmente interesante para su uso directo en la Industria Alimentaria. Gracias a su capacidad emulsionante natural, estos ingredientes pueden ser incorporados sin necesidad de aplicar procesos adicionales de emulsificación, que suelen ser costosos y complejos, facilitando así el desarrollo de alimentos más sostenibles y con menor procesamiento industrial. En esta línea, se plantea continuar avanzando en mejoras a nivel de acondicionamiento previo del material de partida, así como a nivel de proceso en términos de rendimiento, escalabilidad, y estabilidad de los oleosomas obtenidos.
Desarrollo de oleogeles proteicos: aceites vegetales gelificados con proteínas
En línea con uno de los objetivos del proyecto BOILÀ, esto es, desarrollar ingredientes grasos que ofrezcan las mismas propiedades tecnológicas que los tradicionales, pero con un perfil más saludable y sostenible, se han llevado a cabo procesos oleogelación de aceites.
En concreto, se ha desarrollado la oleogelación proteica, que consiste en emplear proteínas como agentes estructurantes para transformar aceites vegetales líquidos en geles oleosos con propiedades similares a las grasas sólidas, pero sin alterar su perfil nutricional.
En los procesos de oleogelación es habitual el empleo de gomas y otros hidrocoloides como agentes estructurantes. Por ello, aunque el uso de proteínas ha supuesto un reto innovador, proporciona mejoras no sólo a nivel de etiquetado, sino también nutricional.
Para ello, en el presente proyecto, se han evaluado diferentes metodologías atendiendo, asimismo, a la naturaleza de los ingredientes proteicos. En este sentido, se han comparado diferentes fuentes de proteínas, con el fin de identificar aquellas con mayor capacidad para formar redes tridimensionales estables capaces de inmovilizar la fase oleosa. Asimismo, se ha atendido a variaciones en la formulación (ratio agua, aceite y proteína), así como en las etapas y condiciones operativas empleadas, con la finalidad de obtener prototipos con buena consistencia y textura, sin sinéresis, y con buena aptitud tecnológica y sensorial para su posterior incorporación en matrices alimentarias.
Gracias a ello, se ha podido concluir que la oleogelación indirecta con proteínas permite generar nuevas estructuras grasas similares a las sólidas, empleando aceites vegetales, como el de girasol, rico en ácidos grasos insaturados, y sin necesidad de emplear hidrocoloides mejorando así, además, el etiquetado de los productos que las contienen.
Fermentación de microorganismos para la generación de grasas sostenibles (Single Cell Oils)
Una de las actividades desarrollados en el proyecto BOILÀ ha sido el estudio de la producción de Single Cell Oils (SCO). Los SCO son lípidos producidos por microorganismos oleaginosos, los cuales almacenan intracelularmente entre un 20% y un 80% de lípidos, en base seca, en condiciones de crecimiento específicas. Estos microorganismos oleaginosos incluyen especies de bacterias, levaduras, hongos y microalgas cuyo perfil de ácidos grasos de SCO varía en función de la especie seleccionada, lo que los convierte en una alternativa interesante para diversas aplicaciones industriales.
Por un lado, los SCO se presentan como un sustituto apto y eficaz a los aceites obtenidos a partir de fuentes vegetales y animales (principalmente, pescado) para su incorporación en matrices alimentarias, ya que cuentan con características organolépticas y funcionales similares. Por otro lado, representan una alternativa más respetuosa con el medio ambiente, así como más eficiente en términos de proceso de producción, puesto que su producción no depende de la estación, del clima, ni de la ubicación. Asimismo, esta estrategia cuenta con otras ventajas: puede llevarse a cabo empleando una amplia gama de fuentes de carbono, como aquellas derivadas de subproductos de la industria agroalimentaria, y tanto sus rendimientos de producción como la composición de ácidos grasos producidos pueden mejorarse mediante la modificación genética de las cepas.
En el marco del proyecto BOILÀ, se ha llevado a cabo un cribado de microorganismos productores de SCO en los que se ha estudio tanto su crecimiento como sus rendimientos de producción a escala de matraz, en medios de cultivo óptimos definidos para dicho fin. Aquellos microorganismos que han presentado mejores rendimientos de producción han sido seleccionados para optimizar su crecimiento y rendimientos en biorreactor de tanque agitado de 1L, obteniéndose resultados prometedores que constituyen una base sólida para nuevas investigaciones, avanzar en el escalado del proceso, y desarrollar operaciones de acondicionamiento en la continuidad del proyecto.
Estudio de nuevas estructuras vegetales como fuente de aceites
Uno de los planteamientos de este proyecto ha consistido en el establecimiento de líneas celulares de origen vegetal que permitiesen producir aceites de gran calidad en condiciones de cultivo in vitro. Para ello, y partiendo de olivos sanos utilizados para la producción de aceite, se ha obtenido material de partida de hojas, tallos y meristemos, proporcionados por la empresa colaboradora Aceitunas Cazorla, los cuales han sido sometidos a diferentes tratamientos para inferir qué material, así como qué condiciones, son los óptimos para iniciar y establecer líneas celulares de olivo.
De esta forma, se ha desarrollado la metodología idónea para esterilizar el material de partida y establecer cultivos in vitro de callos de olivo en condiciones axénicas, abriendo la ventana al uso de estas estructuras para la producción de grasas vegetales de alto valor, como paso para eliminar la necesidad de cultivos agrícolas tradicionales. Todo ello ha establecido las bases para la segunda anualidad del proyecto.


Alternativas reales a las grasas sólidas: aplicación industrial en matrices alimentarias
Con el fin de evaluar la aplicación de las nuevas grasas generadas en el marco del proyecto BOILÀ se ha llevado a cabo su aplicación en un entorno real. Para ello, las empresas de la Comunitat Valenciana colaboradoras en el proyecto han trabajado en la evaluación y aplicación en varios de sus productos. En concreto, Postres Lácteos Romar ha incorporado varias de estas grasas en sus matrices lácteas, mientras que Cárnicas Serrano ha aplicado oleogeles proteicos en sus matrices cárnicas. Gracias a estas colaboraciones, ha sido posible identificar las propiedades que dichas estructuras confieren al producto, así como las posibles limitaciones de las mismas en función de la matriz alimentaria de aplicación.
En definitiva, el proyecto BOILÀ nos ha permitido desarrollar nuevas grasas con menor impacto ambiental frente a las tradicionales, mejor perfil nutricional, y con buena funcionalidad tecnológica y sensorial. Por todo ello, los resultados obtenidos suponen un avance hacia una alimentación más saludable y sostenible dando respuesta, asimismo, a las demandas de los consumidores en términos de calidad. Además, ha permitido detectar vías de mejora para poder llegar a aplicar estas estructuras en un entorno real, y sentar así las bases para seguir profundizando en este campo con la continuidad del proyecto.
Cabe destacar que el proyecto BOILÀ se ha desarrollado gracias a la financiación de la convocatoria IVACE-FEDER de la Conselleria d’Economia Sostenible, Sectors Productius, Comerç i Treball, dirigida a centros tecnológicos de la Comunitat Valenciana para el desarrollo de proyectos de I+D de carácter no económico, realizados en colaboración con empresas.